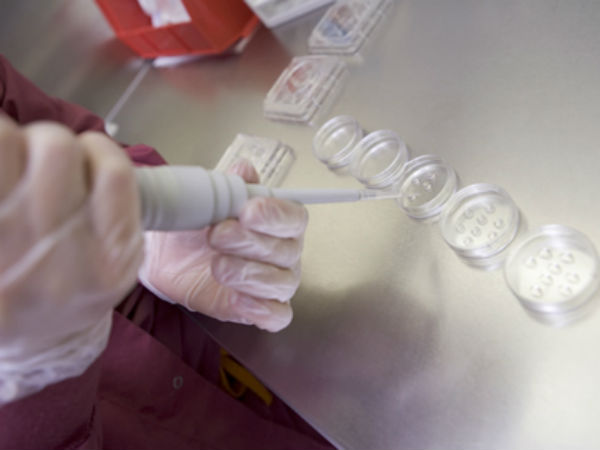
எவ்வளவு காலம் :

Latest Updates
-
கொத்தமல்லி மாங்காய் சாதமும், உருளைக்கிழங்கு வறுவலும் - 15 நிமிடத்தில் எப்படி செய்றது-ன்னு பாருங்க.. -
உஷார்.. இந்த 5 உணவுகள் ஒருவரது ஆயுளை பாதியாக குறைக்குமாம்.. எச்சரிக்கும் டாக்டர். பிள்ளை! -
கடகம் செல்லும் சுக்கிரன்: ஜூன் 08 முதல் இந்த 3 ராசிக்காரர்களின் அதிர்ஷ்டம் பிரகாசிக்கப்போகுது.! -
இந்த கஞ்சியை தினமும் காலையில் 1 கப் குடிங்க.. உடல் எடை குறையும், நாள் முழுவதும் சுறுசுறுப்பாகவும் இருப்பீங்க.. -
இன்றைய ராசிபலன் 04 ஜூன் 2026: இன்று இந்த 3 ராசிக்காரர்களுக்கு நல்ல செய்தி தேடிவருமாம் -
குருபெயர்ச்சியால் உருவாகும் கஜகேசரி ராஜயோகம்: இந்த 4 ராசிகளுக்கு கூரையை பிச்சுட்டு அதிர்ஷ்டம் கொட்டப்போகுதாம் -
10 வரமிளகாயும், சின்ன வெங்காயமும் இருந்தா இந்த கர்நாடகா கெம்பு சட்னியை அரைங்க - சுருக்குனு சூப்பரா இருக்கும் -
பாபா வாங்காவின் கணிப்பு படி 2026-ன் பிற்பகுதியில் உலகில் என்னென்ன சம்பவங்கள் நடக்கப்போகுது தெரியுமா? -
டெல்லியை ஆண்ட முதல் சுல்தான் யார்? அவர் எந்த வம்சத்தை சேர்ந்தவர் தெரியுமா? -
ஆந்திராவின் அட்டகாசமான வெஜ் புலாவ் ரெசிபி - ஒருதடவை செஞ்சு பாருங்க - தாறுமாறா இருக்கும்
கருமுட்டை தானம் குறித்து நீங்கள் அவசியம் தெரிந்து வைத்திருக்க வேண்டியவை!
கருத்தரிக்க முடியாத தம்பதிகள் கருமுட்டையை தானமாக பெற்று செயற்கை கருத்தரித்தல் மூலமாக குழந்தை பெற்றுக் கொள்ள முடியும்.
ஒவ்வொரு மாதமும் பெண்ணின் மாதவிடாய் நாட்களின்போது கருமுட்டைகள் உற்பத்தியாகின்றன. அவை கருவாக மாறாத நிலையில் வெளியேறுகின்றன. அவற்றை தானமாகப் பெற்று, கணவனின் விந்தணுவுடன் இணைத்து, செயற்கை முறை கருத்தரித்தல் முறையில் கரு உருவாக்கி, சம்பந்தப்பட்ட மனைவியின் கர்ப்பப் பையில் வைத்து சிசுவை வளர்க்கிறார்கள்!
இந்தியாவில் 1986 ஆண்டுக்கு பிறகு கருமுட்டை தானம் அறிமுகமானது. கருமுட்டை தானம் செய்வது தொடர்பாக இங்கு சட்ட விதிமுறைகள் எதுவும் இல்லை என்பது குறிப்பிடத்தக்கது.

யாருக்கு தேவை ? :
ஒரு பெண் கருத்தரித்தலில் ஏற்படும் பிரச்சனைகள் காரணமாக கருமுட்டை தானமாக பெறப்படுகிறது. இதன் மூலம் சோதனைக் குழாய் முறையில் கருத்தரிக்க முடியும். ஒரு பெண்ணுக்கு கருமுட்டை உருவாக்கத்தில் ஏற்படும் பிரச்சினைகள், சினைப்பை முழுவதுமாக பாதிக்கப்பட்ட நிலையில் இருக்கும் பெண்கள்,
கருமுட்டை உருவாகாத நிலையை அடையாமல் சிதைந்து போகும் நிலையில் இருப்பவர்கள் போன்றவர்களுக்கு கருமுட்டை தானமாகப் பெறப்படுகிறது.
இது மட்டுமல்லாமல், பாரம்பரிய குறைபாடு கொண்டவர்கள் தங்களது கருமுட்டையைப் பயன்படுத்தாமல், இன்னொரு பெண்ணிடமிருந்து கருமுட்டையை தானமாகப் பெற்று கருத்தரிக்க விரும்புவார்கள்.

யாரெல்லாம் கருமுட்டை தானம் கொடுக்கலாம் ? :
கருமுட்டை தானம் கொடுக்கும் பெண் 25 முதல் 30 வயதுக்குள்ளும் ஆரோக்கியமானவராகவும் இருக்க வேண்டும். கருமுட்டை உண்டாவதற்காக அந்தப் பெண்ணுக்கு 10 நாட்களுக்கு ஹார்மோன் மாத்திரை அல்லது ஊசி கொடுக்கப்படும்.
அதனை ஏற்றுக்கொள்ளக்கூடிய ஆரோக்கியமான உடல்வாகு கொண்டவராக இருப்பது அவசியம்.

சோதனைகள் :
கருமுட்டை பெறப்படும் சூழலில் ஹெபடைட்டிஸ் கிருமிகள் இருக்கின்றனவா, ஹெச்.ஐ.வி மற்றும் பால்வினை நோய்கள் ஏதேனும் இருக்கின்றனவா என்பதெல்லாம் சோதிக்கப்படும். இதற்கான கட்டணங்களை கருமுட்டை தானம் பெறுகிறவரே ஏற்றுக்கொள்ள வேண்டும். இதில் கவனிக்க வேண்டிய ஒரு விஷயம்... கருமுட்டை தானம் தந்தவர் சட்டரீதியாக குழந்தைக்கு உரிமை கொண்டாட முடியாது.

கருமுட்டை சேகரிப்பு :
ஒரு பெண்ணுக்குக் கருமுட்டை உற்பத்தியைத் தூண்ட ஹார்மோன் ஊசிகள் போடும்போது, அவை ஒன்றுக்கு மேலான முட்டைகளை உருவாக்கும். குழந்தை உருவாக ஒரு முட்டை மட்டுமே தேவை. ஆனால், அதற்கு ஒரு முட்டையை மட்டுமே நம்ப முடியாது. முட்டைகள் நிறைய இருந்தால்தான் சில கருக்களாவது கிடைக்கும்.
ஏனென்றால், எல்லா கருக்களுமே ஆரோக்கியமாக இருக்கும் எனச் சொல்ல முடியாது. அதிகபட்சம் இரண்டு முதல் மூன்று கருக்கள் வரை கருப்பையினுள் வைக்கப்படும்.

உறைநிலையில் கருமுட்டை :
பத்து கருக்களாவது கிடைத்தால்தான் அவற்றிலிருந்து ஆரோக்கியமான இரண்டோ, மூன்றோ தேர்ந்தெடுக்க முடியும். குறைந்தது பத்து முட்டைகளாவது வந்தால்தான், அவற்றிலிருந்து தரமான எட்டு கருக்களாவது உருவாக்க முடியும். அவற்றில் அதிகபட்சமாக மூன்று கருக்களைக் கருப்பையில் வைத்துவிட்டு, மீதம் உள்ளவற்றை உறைநிலையில் வைக்கப்படும்.

கருவை உறைய வைக்க தனிக்கட்டணம் :
ஒருவேளை இந்தச் சிகிச்சையில் சம்பந்தப்பட்ட பெண்ணுக்குக் குழந்தை கிடைக்கவில்லை என்றால், அடுத்த முறை அதே கருவை உபயோகித்துக்கொள்ள முடியும்.
அந்த முறையிலேயே குழந்தை கிடைத்துவிட்டால், மிச்சம் இருக்கும் கருவுக்கு, தானம் பெற்ற பெண் மட்டுமே சொந்தம் கொண்டாட முடியும். அந்தக் கருவை உறையவைக்க மருத்துவமனைக்கு வருடம்தோறும் குறிப்பிட்ட தொகையைச் செலுத்த வேண்டும்.
எவ்வளவு காலம் :
கருமுட்டை ஒரு பெண் உடலில் இருந்து எடுக்கப்படும் போது, 37 டிகிரி செண்டிகிரேட் வெப்பத்தில் இருக்கும் அதனை மைனஸ் 194 செண்டிகிரேடுக்கு மாற்றி லிக்விட் நைட்ரஜனில் உறைய வைக்கப்படும். இதனை க்ரையோலாஜிக் என்று சொல்லப்படும். இதனை எத்தனை வருடங்கள் வேண்டுமானாலும் பாதுகாக்கலாம்.

மேற்கத்திய நாடுகள் :
மேற்கத்திய நாடுகளில் உறவினர்கள் மற்றும் நண்பர்களுக்கிடையில் முட்டை தானம் அனுமதிக்கப்படுகிறது. இந்தியாவில் தானம் கொடுப்பவரும் பெறுபவரும் ஒருவரை ஒருவர் தெரிந்தவராக இருப்பதை அனுமதிப்பதில்லை.
கருமுட்டை தானம் கொடுப்பவருக்கு மருத்துவரும் உளவியல் நிபுணரும் கவுன்சலிங் செய்வார்கள். திருமணமானவர் என்றால் கணவருக்கும் கவுன்சலிங் உண்டு.

ஹார்மோன் ஊசிகள் :
கருமுட்டை வளர்ச்சியை தூண்ட போடப்படும் கொனடோட்ரோஃபின் ஹார்மோன் என்பது, முட்டையின் வளர்ச்சிக்கு ஏற்ப 150 மி.லி முதல் அதிகபட்சமாக 300 மி.லி வரை கொடுக்கப்படும். ஐ.யு.ஐ சிகிச்சையில் எத்தனை முட்டைகள் வந்தாலும், அவற்றின் வளர்ச்சி 18 மி.மீ இருக்கிறதா என்பதே முக்கியமாகப் பார்க்கப்படும்.
இந்தச் சிகிச்சையில் முட்டைகளின் எண்ணிக்கையை அதிகப்படுத்தவும் அதிக அளவில் கொனடோட்ரோஃபின் கொடுக்கப்படும். அப்படிக் கொடுக்கும்போது ஸ்கேன் செய்து ஹார்மோன் அளவுகளைச் சரிபார்க்க வேண்டும். ஈஸ்ட்ரோஜன் அதிகமாக இருந்தாலோ, நிறைய முட்டைகள் இருந்தாலோ, அதற்கு முன்னர் `ஓ.ஹெச்.எஸ்' எனப்படும் ஓவேரியன் ஹைப்பர் ஸ்டிமுலேஷன் (OHS)பிரச்னை வந்திருந்தாலோ... ஹார்மோன் கொடுப்பதை நிறுத்துவது நல்லது.

கருமுட்டை :
18 மி.மீ அளவுக்கு வளர்ந்ததும் அந்த முட்டை உடைய வேண்டும். அதற்காக ஹெச்.சி.ஜி ஹார்மோன் கொடுக்க வேண்டியிருக்கும். அப்போதுதான் முட்டை உடைந்து உள்ளிருந்து திரவம் வெளியே வரும். அதைத்தான் `கருமுட்டை வெளிப்படுதல்' (ஓவுலேஷன்) என்கிறோம்.
ஓ.ஹெச்.எஸ் வருவதற்கான அறிகுறிகள் தெரிந்தால், ஹெச்.சி.ஜி-யை நிறுத்த வேண்டும்.

டோனர்கள் :
தாங்கள் விரும்பும் நிறத்தில், உயரத்தில் குழந்தை பெற விரும்பும் தம்பதியர், தங்களது தேவைகளைக் குறிப்பிட்டு, அதற்கு ஏற்ற டோனர்களைத் தேடுவதும் நடக்கிறது. அதேபோல வெளிநாடுவாழ் மக்களுக்கும், இந்தியாவிலிருந்து கருமுட்டை விற்பனை அமோகமாக நடக்கிறது.
அம்மா அல்லது அப்பாவின் சாயல் கொஞ்சமாவது வேண்டும் என்பதால், அப்படிப்பட்ட சாயலில் உள்ள டோனர் பெண்களைத் தேடும் வேலையும் நடக்கிறது. இதற்காக தானம் கொடுக்கும் பெண்களின் புகைப்படங்கள், தானம் பெறுகிறவர்களுக்கு அனுமதியின்றி காட்டப்படுகிறது.

எச்சரிக்கை :
ஒரு பெண் ஆறு முறைக்கு மேல் கருமுட்டை தானம் செய்வது ஆபத்தானது. ஒரு முறை தானம் செய்வதற்கும் அடுத்த முறை தானம் செய்வதற்கும் இடையில் குறைந்தது ஆறு மாதங்கள் வரையாவது இடைவேளி இருக்க வேண்டும்.
கருமுட்டை வளர்ச்சியைத் தூண்டுவதற்காகக் கொடுக்கப்படும் கொனடோட்ரோஃபின் ஹார்மோன் அளவு கொஞ்சம் அதிகமானாலும், உயிரே பறிபோகும் அபாயம் இருக்கிறது. அடிக்கடி கருமுட்டை தானம் செய்தால் கருப்பைப்பை புற்றுநோய் வருவதற்கு அதிக வாய்ப்புகள் உண்டு.



Click it and Unblock the Notifications